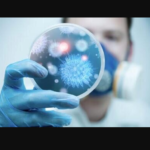
فرارو | ویروسها ارتعاشات صوتی دارند فرارو | ویروسها ارتعاشات صوتی دارند

کشف منشأ حیات با هوش مصنوعی!
در پژوهشی جدید که نتایج آن در AGU Advances منتشر شده، تیمی به رهبری مؤسسه تحقیقات منظومه شمسی ماکس پلانک (MPS)، دقیقترین تحلیل روی ترکیبات آلی سرس و ویژگیهای زمینشناختی آنها را ارائه داده است. به گزارش دیجیاتو؛ دانشمندان با استفاده از هوش مصنوعی و دادههای جمعآوریشده با فضاپیمای داون ناسا (Dawn)، اسکن دقیقی از […]